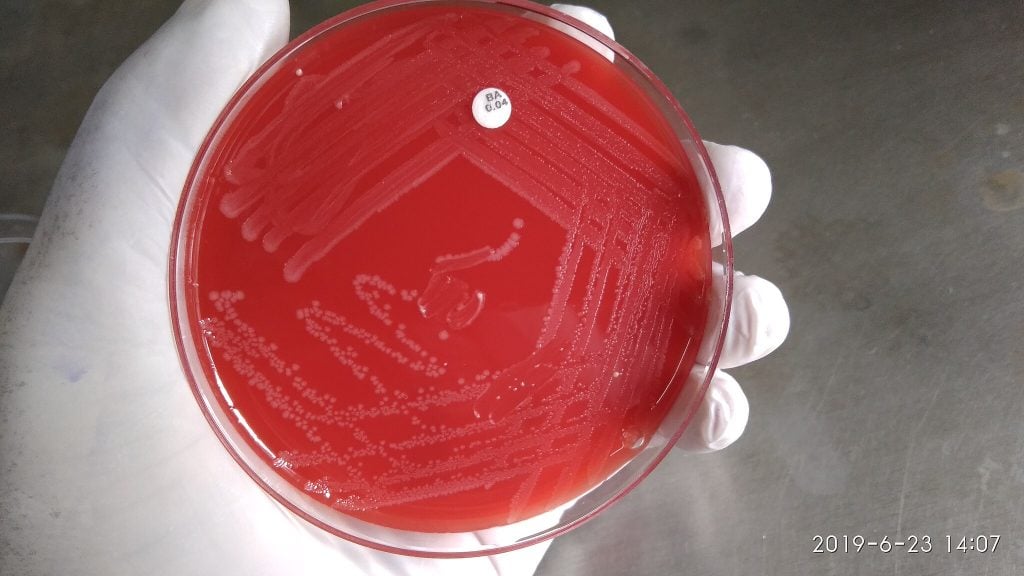
Ανησυχητική αύξηση σοβαρών τροφικών δηλητηριάσεων από ανθεκτικό βακτήριο στην Ευρώπη

Αυξήθηκαν στην Ευρώπη τα περιστατικά σοβαρής τροφικής δηλητηρίασης που σχετίζονται με το βακτήριο Listeria, πιθανώς λόγω των αλλαγών στις διατροφικές συνήθειες και της γήρανσης του πληθυσμού, προειδοποιούν υγειονομικές και αρμόδιες αρχές για την ασφάλεια τροφίμων.
Το 2024 καταγράφηκαν περισσότερα από 3.000 επιβεβαιωμένα κρούσματα από Listeria, με περίπου το 70% να χρειάζεται νοσηλεία και έναν στους 12 ασθενείς να καταλήγει, σύμφωνα με νέα έκθεση του Ευρωπαϊκού Κέντρου Πρόληψης και Ελέγχου Νοσημάτων (ECDC) και της Ευρωπαϊκής Αρχής για την Ασφάλεια των Τροφίμων (EFSA).
Το Listeria είναι ένα βακτήριο που ευδοκιμεί σε υγρά, δροσερά περιβάλλοντα και μπορεί να είναι δύσκολο να εξαλειφθεί ακόμη και με εντατικές διαδικασίες απολύμανσης. Οι λοιμώξεις, που μεταδίδονται συχνά μέσω τροφίμων, είναι σπάνιες αλλά δυνητικά θανατηφόρες. Έως και το 3% των έτοιμων προς κατανάλωση τροφίμων εμφανίζουν επίπεδα μόλυνσης από Listeria πάνω από τα όρια ασφάλειας της ΕΕ, σύμφωνα με την έκθεση. Τα λουκάνικα είναι τα συχνότερα μολυσμένα προϊόντα.
«Παρόλο που η μόλυνση είναι σπάνια, το Listeria μπορεί να προκαλέσει πολύ σοβαρή ασθένεια, γεγονός που το καθιστά μία από τις πιο επικίνδυνες τροφιμογενείς απειλές που παρακολουθούμε», δήλωσε ο Όλε Χόιερ, επικεφαλής του τομέα του ECDC που συνδέει την ανθρώπινη, ζωική και περιβαλλοντική υγεία.
Η έκθεση παρακολούθησε λοιμώξεις από Listeria, Salmonella, Campylobacter, E. coli που παράγει τοξίνη Shiga (STEC) και άλλα βακτήρια σε χώρες της Ευρωπαϊκής Ένωσης, στο Ηνωμένο Βασίλειο, καθώς και σε οκτώ ακόμη μη κράτη-μέλη της ΕΕ. Το 2024 καταγράφηκαν6.558 τροφιμογενείς επιδημίες, αύξηση 14,5% σε σχέση με το προηγούμενο έτος. Ωστόσο, παρότι τα κρούσματα και οι νοσηλείες αυξήθηκαν, οι θάνατοι μειώθηκαν.
Οι πιθανές αιτίες
Η «ανοδική τάση» των τροφιμογενών λοιμώξεων οφείλεται πιθανότατα σε συνδυασμό παραγόντων, αναφέρει η έκθεση, όπως οι μεταβαλλόμενες διατροφικές συνήθειες – για παράδειγμα, η αυξημένη κατανάλωση έτοιμων γευμάτων – η μη υγιεινή διαχείριση τροφίμων και η γήρανση του πληθυσμού, που καθιστά περισσότερους ανθρώπους ευάλωτους.
Το 2024, τα λαχανικά και άλλα μη ζωικά προϊόντα συνδέθηκαν με τους περισσότερους θανάτους από τροφικές δηλητηριάσεις, με ισχυρές ενδείξεις σχετικά με την προέλευσή τους. Ωστόσο, η σαλμονέλα ήταν υπεύθυνη για τις περισσότερες πολυεθνικές επιδημίες, με τα αυγά και τα προϊόντα αυγών να αποτελούν τον κύριο φορέα μετάδοσης
Οι ευρωπαϊκές υπηρεσίες ανέφεραν ότι έχει σημειωθεί «σημαντική αύξηση» των λοιμώξεων από σαλμονέλα σε πτηνοτροφικές μονάδες την τελευταία δεκαετία και ότι πολλές χώρες της ΕΕ δεν λαμβάνουν επαρκή μέτρα αντιμετώπισής τους.
«Φέτος, σημαντικός αριθμός χωρών της ΕΕ δεν πέτυχε όλους τους στόχους για τη μείωση της σαλμονέλας στα πουλερικά, με μόλις 14 κράτη-μέλη να επιτυγχάνουν πλήρη συμμόρφωση», δήλωσε ο Φρανκ Βέρντονκ, επικεφαλής του τμήματος βιολογικών κινδύνων και υγείας και ευημερίας των ζώων της EFSA.
Οδηγίες προστασίας
Οι υπηρεσίες τόνισαν ότι οι πολίτες μπορούν να λάβουν μέτρα για να προστατευθούν από τροφιμογενείς λοιμώξεις, όπως να διατηρούν το ψυγείο στους 5°C ή χαμηλότερα, να καταναλώνουν τα έτοιμα γεύματα πριν από την ημερομηνία λήξης, να μαγειρεύουν καλά το κρέας, να μην αναμειγνύουν μαγειρεμένα και ωμά τρόφιμα, και να πλένουν χέρια τους, καθώς και τα εργαλεία και τις επιφάνειες μετά τον χειρισμό ωμών προϊόντων.
Πρόσθεσαν επίσης ότι οι «ευάλωτες ομάδες» – όπως οι ηλικιωμένοι, οι έγκυες γυναίκες και τα άτομα με εξασθενημένο ανοσοποιητικό σύστημα– πρέπει να «αποφεύγουν τρόφιμα υψηλού κινδύνου» όπως έτοιμα γεύματα, μη παστεριωμένο γάλα και μαλακά μη παστεριωμένα τυριά.
ΠΗΓΗ: Euronews